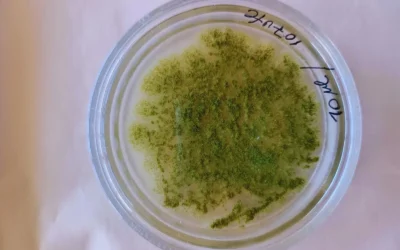
Desarrollan un extracto vegetal con poder antifúngico

La hipótesis de país grande ¿de nuevo?
La potencial imposición de aranceles en Estados Unidos a China, México, Canadá y la Unión Europea trae nuevas turbulencias al comercio mundial. ¿Cuál es la importancia de estos países para la Argentina?
El Crushing de soja vuelve a máximos históricos
El procesamiento de la oleaginosa rompe récords en diciembre y confirma la buena actividad de la industria. La fuerte demanda por maíz impulsa aún más los embarques del cereal, que le ganan la pulseada a las exportaciones de trigo.
Mercado chino: El año nuevo abre un impasse comercial en medio de un posible cambio de reglas
En 2024, China alcanzó un nuevo récord en volumen importado al reportar ingresos por un total de 2,875 millones de toneladas de carne vacuna. Esto es un 5% más que lo importado en 2023 y el máximo volumen hasta entonces registrado.
Desarrollan un extracto vegetal con poder antifúngico
Un equipo de investigación del INTA, del Conicet y de la Universidad de Buenos Aires avanza en el desarrollo de un producto biológico para controlar un hongo que produce micotoxinas que afectan a los granos almacenados.
La agroindustria argentina no tiene fronteras: en 2024 exportó a más de 130 países
En 2024, las exportaciones agroindustriales argentinas desembarcaron en 132 países, más de la mitad del planeta, consolidando el país como un proveedor global de alimentos y materias primas.
Los embarques de granos, subproductos y aceites crecieron un 60% en 2024
Entre enero y diciembre del 2024 se despacharon 89,3 millones de toneladas (Mt) de productos agroindustriales desde los puertos argentinos. La región del Up-River (Rosario) fue responsable del 76% de los envíos, y más de la mitad de la mercadería tuvo como destino el continente asiático.
En 2024, las exportaciones de las economías regionales crecieron 23,8% en dólares y 25,7% en toneladas
El precio promedio de exportación de las economías regionales argentinas se ubicó en USD 1.191 por tonelada, observándose una baja del 1,5% con respecto al año 2023, fruto de la caída de los precios internacionales.
El anuncio de la baja temporal de las retenciones revolucionó el mercado de granos
Desde el anuncio, en el mercado casi no se ha hablado de nada más que no sea del impacto de la medida en precios y comercialización. Sin embargo, no hay que perder de vista la urgente necesidad de milímetros de agua y el silencioso avance de la chicharrita.
Cinco dudas frecuentes sobre la exportación de granos en Argentina
La exportación de granos, harinas y aceites es muy relevante para la macroeconomía nacional. Sin embargo, desconocer algunas características intrínsecas de la actividad puede conducir a errores de diagnóstico.
Recuperación de los ingresos: el desafío por delante
A medida que se avanza hacia 2025, el gobierno debe lograr armonizar las políticas fiscales, sociales y laborales de manera coherente y efectiva, para asegurar la sostenibilidad de los ingresos y reducir las desigualdades estructurales que aún persisten en el país.
China está cambiando su política de importación en el sector lácteo
China está cambiando su política de importación en el sector lácteo. Más crema y manteca, cuyo crecimiento de las importaciones está ligado a un mejor poder adquisitivo de un segmento de los consumidores chinos.
Año récord para el mercado de capitales argentino
En 2024 se realizaron transacciones por $ 14,4 billones en el MAV, alcanzando un volumen sin precedentes. El crecimiento es explicado por una mayor operación de instrumentos en pesos, con el pagaré como principal instrumento de negociación.
Exportaciones argentinas 2024: las cadenas agroindustriales al frente, con el sector energético en ascenso
En 2024, Argentina exportó bienes por más de 79 mil millones de dólares, con la agroindustria explicando más de la mitad. Sectores como el petróleo, metales y minerales alcanzaron máximos en 20 años.
Las exportaciones de trigo escalan un 87% respecto al año pasado
De la mano de la recuperación productiva y las toneladas que pasan de la campaña anterior, los envíos al exterior estuvieron cerca de duplicarse. Sin embargo, la caída en los precios internacionales limitó el valor de las exportaciones locales.